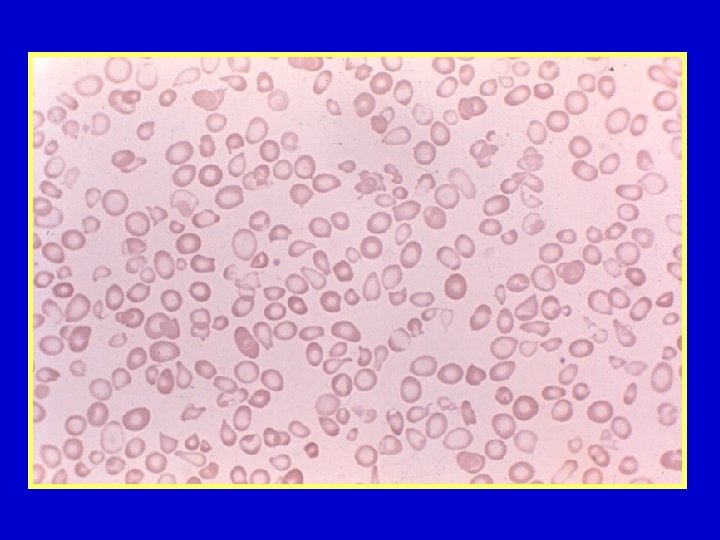

IL GLOBULO ROSSO NORMALE I GLOBULI ROSSI O


IL GLOBULO ROSSO NORMALE I GLOBULI ROSSI (O ERITROCITI O EMAZIE) SONO IL COMPONENTE PRINCIPALE DEL SANGUE. SONO CORPICCIOLI ROTONDI, DI GRANDEZZA MICROSCOPICA, TUTTI EGUALI, RIPIENI DI UNA SOSTANZA LIQUIDA: L’EMOGLOBINA, CHE DÀ IL COLORE ROSSO AL SANGUE E CHE HA IL COMPITO DI PORTARE L’OSSIGENO A TUTTE LE CELLULE. LA MOLECOLA EMOGLOBINICA È COMPOSTA DA 4 CATENE GLOBINICHE DIVERSE TRA LORO PER L’ORDINAMENTO DELLE MOLECOLE DI AMINOACIDI CHE LE COMPONGONO. SI DISTINGUONO: CATENE a (ALFA), b (BETA), d (DELTA), g (GAMMA).

LE EMOGLOBINE UMANE NORMALI VI SONO TRE TIPI DI EMOGLOBINA UMANA NORMALE: L’Hb A CHE È PROPRIA DELL’INDIVIDUO DOPO LA NASCITA, COSTITUISCE IL 98% DI TUTTA L’EMOGLOBINA ED È COMPOSTA DA 2 CATENE GLOBINICHE a E 2 b; L’Hb A 2, CHE È ANCH’ESSA PRESENTE SOLO DOPO LA NASCITA, È COMPOSTA DA 2 CATENE a E 2 d, E COSTITUISCE IL RESTANTE 2%; L’EMOGLOBINA FETALE (Hb F) CHE È PROPRIA DEL PERIODO DELLA VITA INTRAUTERINA ED È’ FORMATA DA 2 CATENE a E 2 g.

I “GENI” GLOBINICI COME PER OGNI ALTRO CARATTERE EREDITARIO, ANCHE PER IL CARATTERE “EMOGLOBINA” E PIÙ PRECISAMENTE PER OGNI TIPO DI CATENA GLOBINICA (a, b, d, g) ESISTONO NEL DNA DI CIASCUN INDIVIDUO UNA O DUE COPPIE DI GENI, TRASMESSI UNO DAL PADRE E UNO DALLA MADRE E CHE A SUA VOLTA L’INDIVIDUO TRASMETTERÀ AI PROPRI FIGLI.

I GENI GLOBINICI HANNO UNA BEN PRECISA DISTRIBUZIONE IN UN TRATTO DI DNA DEI CROMOSOMI 11 E 16. I GENI e (EPSILON) E z (ZETA) SONO ATTIVI SOLO NELLA PRIMA FASE DELLA VITA INTRAUTERINA. I GENI COMPLETAMENTE BIANCHI SONO PSEUDOGENI, CHE NON FUNZIONANO. OGNI GENE È COMPOSTO DA 3 ESONI (IN ROSSO) CHE SONO I TRATTI DI DNA CHE VENGONO TRADOTTI IN CATENA GLOBINICA E 2 INTRONI (CIOÈ I TRATTI INTERCALARI, CONTRASSEGNATI IN BIANCO) CHE INVECE NON SONO TRADOTTI IN GLOBINA.

LA MOLECOLA DI DNA VIENE TRASCRITTA (CIOÈ RICOPIATA) IN UNA IDENTICA MOLECOLA, IL PRE-m. RNA, CHE ATTRAVERSO UN LUNGO PROCESSO DI MATURAZIONE (PROCESSING) VIENE TRASFORMATA IN m. RNA. UNA FASE IMPORTANTE DI QUESTO PROCESSO È LA RIMOZIONE DEGLI INTRONI (SPLICING). L’m. RNA MATURO, DOPO ESSER PASSATO DAL NUCLEO AL CITOPLASMA DELLA CELLULA, SI TRADUCE IN CATENA GLOBINICA. SPLICING

I GENI GLOBINICI NELLE MICROCITEMIE I GENI GLOBINICI HANNO DUNQUE IL COMPITO DI PRODURRE L’EMOGLOBINA: POSSONO PERÒ ESSERE ASSENTI (DELEZIONI) O AVERE DIFETTI DI VARIO GENERE (MUTAZIONI), A CAUSA DEI QUALI NON PRODUCONO PIÙ O PRODUCONO SOLO UNA PICCOLISSIMA QUANTITÀ DI CATENE GLOBINICHE. UNA PARTICOLARE TECNICA (LO STUDIO DELLA SINTESI GLOBINICA IN VITRO) RIVELA CON ESATTEZZA SE È RIDOTTA LA SINTESI DI CATENE b o a.

IL GENE ASSENTE O SCARSAMENTE FUNZIONANTE VIENE DEFINITO MICROCITEMICO O TALASSEMICO E LA CONDIZIONE CHE NE DERIVA È LA MICROCITEMIA O TALASSEMIA. DIFETTI MICROCITEMICI POSSONO ESSER PRESENTI IN TUTTI I GENI GLOBINICI a, b, d, g. I PIÙ IMPORTANTI SONO PERÒ QUELLI DEL GRUPPO b, CHE IN DETERMINATE CONDIZIONI GENETICHE CAUSANO L’ANEMIA MEDITERRANEA E LA TALASSEMIA INTERMEDIA.

I CARATTERI DEL SANGUE MICROCITEMICO g/dl per ml m 3 NELLA MICROCITEMIA LA QUOTA DI EMOGLOBINA È RIDOTTA MENTRE IL NUMERO DI GLOBULI ROSSI È SUPERIORE ALLA NORMA. CIÒ DETERMINA UNA RIDUZIONE NOTEVOLE DELL’EMATOCRITO E DEL VOLUME GLOBULARE MEDIO. IL RIDOTTO CONTENUTO DI EMOGLOBINA DÀ ORIGINE AD UN APPIATTIMENTO DELLE EMAZIE E QUINDI AD UNA LORO MAGGIORE RESISTENZA ALL’EMOLISI IN SOLUZIONE SALINA IPOTONICA.

IN QUESTA SOLUZIONE L’EMOLISI DELLE EMAZIE NORMALI È TOTALE E IL LIQUIDO COLOR ROSA È LIMPIDO; LE EMAZIE MICROCITEMICHE VENGONO DISTRUTTE SOLO IN PARTE E LA SOLUZIONE RESTA TORBIDA.

È TIPICA DEL SANGUE MICROCITEMICO ANCHE UNA SERIE DI ALTERAZIONI MORFOLOGICHE DELLE EMAZIE: ASPETTO PALLIDO, FORMA E GRANDEZZA DIVERSE (MICROCITOSI, POICHILOCITOSI, EMAZIE A BERSAGLIO).

NORMALE MICROCITEMICO

IL QUADRO EMOGLOBINICO NELLE MICROCITEMIE NELLA b MICROCITEMIA LA QUOTA DI Hb A 2 È IL DOPPIO DELLA QUOTA NORMALE (5% O PIU’, ANZICHÈ 2, 5%). NELLA MICROCITEMIA CON Hb LEPORE È PRESENTE UNA QUOTA DELL’ 8 -10% DI UN’EMOGLOBINA PIÙ LENTA DELL’Hb A, E UNA QUOTA NORMALE DI Hb A 2. LA F MICROCITEMIA (O db MICROCITEMIA) È CARATTERIZZATA DA UNA QUOTA DI Hb F DEL 10 -15% E UNA QUOTA DI Hb A 2 NORMALE. NELLE a MICROCITEMIE IL QUADRO EMOGLOBINICO È NORMALE.

ECCO COME SI VEDE ALL’ESAME ELETTROFORETICO L’AUMENTO DI Hb A 2 NEL PORTATORE SANO DI b MICROCITEMIA

ECCO L’ASPETTO ELETTROFORETICO DELL’Hb NEL PORTATORE ETEROZIGOTE DI MICROCITEMIA CON Hb LEPORE E NEL PORTATORE ETEROZIGOTE DI F MICROCITEMIA. Lepore F

ALTERAZIONI MOLECOLARI DEI GENI GLOBINICI NELLE MICROCITEMIE GLI STUDI MOLECOLARI SUL DNA DEI GENI GLOBINICI HANNO MESSO IN LUCE L’ESISTENZA DI NUMEROSISSIME VARIETÀ (ORMAI CIRCA 300) DI MICROCITEMIE a, b, d, g. LE PIÙ FREQUENTI NEI PAESI MEDITERRANEI E IN ITALIA SONO LE PRIME 4 DELLA TABELLA. LA MICROCITEMIA CON Hb E È DIFFUSISSIMA INVECE NEI PAESI ASIATICI.

I DIFETTI MICROCITEMICI DEI GENI GLOBINICI POSSONO ESSERE: l l DELEZIONI; MUTAZIONI PUNTIFORMI CHE COLPISCONO UNO O POCHISSIMI NUCLEOTIDI DEL DNA; MUTAZIONI CHE ALTERANO LA MATURAZIONE DELL’m. RNA; MUTAZIONI CHE DANNO ORIGINE A CATENE GLOBINICHE FORTEMENTE INSTABILI.

EREDITARIETA’ DELLE MICROCITEMIE VENGONO TRASMESSE EREDITARIAMENTE DAI GENITORI AI FIGLI COME CARATTERI MENDELIANI DOMINANTI. SI TRASMETTONO QUINDI SENZA SALTARE GENERAZIONI: SE UN SOGGETTO È PORTATORE DI MICROCITEMIA (figurina metà rossa e metà bianca), ALMENO UNO DEI SUOI GENITORI DEVE ESSERE MICROCITEMICO: E SE È ESENTE DA MICROCITEMIA (figurina tutta bianca), PUR ESSENDO FIGLIO DI UN MICROCITEMICO, NON AVRÀ FIGLI MICROCITEMICI.

IL SOGGETTO CHE HA UN GENE GLOBINICO NORMALE (PER ESEMPIO IL GENE b) E UNO MICROCITEMICO, È IL PORTATORE ETEROZIGOTE DI MICROCITEMIA. È UN SOGGETTO SANO ANCHE SE SPESSO È UN PO’ PALLIDO E ASTENICO. PUÒ SVOLGERE QUALSIASI LAVORO, STUDIARE, AVERE FIGLI.

IL MALATO DI ANEMIA MEDITERRANEA È INVECE IL SOGGETTO CHE HA RICEVUTO DAI GENITORI DUE GENI b MICROCITEMICI: È IL PORTATORE OMOZIGOTE DI MICROCITEMIA.

IN BASE ALLA LEGGE MENDELIANA NELLE FAMIGLIE CON UN GENITORE MICROCITEMICO E UNO NORMALE IL 50% DEI FIGLI SONO NORMALI E IL 50% MICROCITEMICI SANI, MENTRE NELLE FAMIGLIE CON ENTRAMBI I GENITORI MICROCITEMICI IL 25% DEI FIGLI È ESENTE DA MICROCITEMIA, IL 50% È PORTATORE ETEROZIGOTE SANO, IL 25% È AFFETTO DA ANEMIA MEDITERRANEA.

NELLE SINGOLE FAMIGLIE QUESTE PERCENTUALI POSSONO ESSERE, PER PURO CASO, DIVERSE. RESTA PERÒ LA REGOLA FONDAMENTALE CHE NELLE FAMIGLIE CON ENTRAMBI I GENITORI MICROCITEMICI VI È AD OGNI GRAVIDANZA IL 25% DI RISCHIO CHE NASCA UN FIGLIO MALATO. ECCO ALCUNI CASI

QUESTA È LA NOZIONE FONDAMENTALE DI GENETICA CHE STA ALLA BASE DEL CONCETTO DI PREVENZIONE DELL’ANEMIA MEDITERRANEA E CHE VIENE TRASMESSA A TUTTA LA POPOLAZIONE IN ETÀ FERTILE NEL CORSO DEI PROGRAMMI DI PREVENZIONE E SOPRATTUTTO AGLI STUDENTI DELLE SCUOLE MEDIE NEL CORSO DELLO SCREENING SCOLASTICO.

NOMENCLATURA NELLA LETTERATURA INTERNAZIONALE LE MALATTIE MICROCITEMICHE SONO DI REGOLA DENOMINATE TALASSEMIE. LA MAJOR È L’ANEMIA MEDITERRANEA O MORBO DI COOLEY; LA TALASSEMIA MINIMA È LA MICROCITEMIA, COSÌ DENOMINATA DA SILVESTRONI E BIANCO CHE L’HANNO SCOPERTA IN ITALIA NEL 1943 IN SOGGETTI SANI.

LA DIFFUSIONE GEOGRAFICA DELLE MICROCITEMIE SONO PRESENTI IN TUTTO IL MONDO, MA PARTICOLARMENTE FREQUENTI IN UNA LARGA FASCIA TROPICO-SUBTROPICALE DEI VARI CONTINENTI.

SONO PARTICOLARMENTE FREQUENTI IN TUTTI I PAESI CHE SI AFFACCIANO SUL MEDITERRANEO (DA CUI IL NOME DI ANEMIA MEDITERRANEA) E IN TUTTO IL SUD-EST ASIATICO. SI CALCOLA CHE IN QUESTO VASTO TERRITORIO SIANO PRESENTI CIRCA 180. 000 DI PORTATORI SANI DI MICROCITEMIA E CHE IN ASSENZA DI PREVENZIONE NASCANO OGNI ANNO 70. 000 NUOVI MALATI.

FREQUENZA DELLE MICROCITEMIE IN ITALIA VIVONO CIRCA 2. 500. 000 MICROCITEMICI SANI. I MALATI DI ANEMIA MEDITERRANEA ERANO IN PASSATO PIÙ DI 8. 000. OGGI, GRAZIE ALLA PREVENZIONE, SONO CIRCA 4. 000. IN ASSENZA DI PREVENZIONE, PERÒ, TORNEREBBERO A NASCERE ALMENO 400 MALATI L’ANNO. LA FREQUENZA DEI PORTATORI SANI È ALTISSIMA NELLE REGIONI MERIDIONALI, IN SARDEGNA, IN SICILIA E NELLA REGIONE DELTA PADANO.

MICROCITEMIE E MALARIA L’ESATTA CORRISPONDENZA DEI FOCOLAI MICROCITEMICI CON LE ZONE A FORTE ENDEMIA MALARICA HA SUBITO FATTO SUPPORRE CHE LA CAUSA DELLA PRESENZA DI DETTI FOCOLAI FOSSE LA MALARIA. VERSO QUESTA AFFEZIONE I MICROCITEMICI HANNO INFATTI UNA RESISTENZA MAGGIORE DEI SOGGETTI NORMALI E CIÒ AVREBBE PROVOCATO NEI SECOLI UNA SELEZIONE DEI MICROCITEMICI E, DI CONSEGUENZA, LA COMPARSA DEI FOCOLAI MICROCITEMICI NELLE ZONE MALARICHE.

ESAMI DIAGNOSTICI NELLE MICROCITEMIE LA DIAGNOSI DI MICROCITEMIA NEI PORTATORI SANI RICHIEDE UNA SERIE DI ESAMI, DA ESEGUIRE IN FASI CONSECUTIVE. 1 a FASE: ESAME EMOCROMOCITOMETRICO E MORFOLOGICO DEL SANGUE; STUDIO DELLA RESISTENZA GLOBULARE OSMOTICA; DOSAGGIO DELLA SIDEREMIA; STUDIO ELETTROFORETICO DELL’EMOGLOBINA E DOSAGGIO DELL’Hb A 2. 2 a FASE: STUDIO DELLA GLOBINOSINTESI IN VITRO NEL SOGGETTO ED ESAME DEI SUOI GENITORI. 3 a FASE: STUDIO DEL DNA DEI GENI GLOBINICI. LA 2 a E LA 3 a FASE SI ESEGUONO OVVIAMENTE SOLO NEI CASI IN CUI LA DIAGNOSI DEFINITIVA NON È STATA RAGGIUNTA ATTRAVERSO GLI ESAMI DELLA PRIMA FASE.

L’ANEMIA MEDITERRANEA LA CONDIZIONE GENETICA CHE CAUSA LA MALATTIA È L’OMOZIGOSI PER UN DIFETTO b MICROCITEMICO GRAVE (IN ITALIA MOLTO SPESSO LA MUTAZIONE b° 39 C T) OPPURE L’ETEROZIGOSI MISTA PER 2 DIFETTI b MICROCITEMICI GRAVI. IN QUESTE CONDIZIONI IL BAMBINO NON POSSIEDE NESSUN GENE b GLOBINICO NORMALE E NON È IN GRADO DI PRODURRE Hb ADULTA. SUBITO DOPO LA NASCITA DIVIENE QUINDI FORTEMENTE ANEMICO. È MOLTO PALLIDO, NON HA APPETITO E NON CRESCE.

LA SUA Hb È SOLTANTO Hb. F E SOLO SE EGLI È PORTATORE DI UN GENE MICROCITEMICO b+, È IN PICCOLA QUOTA ANCHE Hb. A.

I SUOI GLOBULI ROSSI SONO ASSAI POCHI E MOLTO PIÙ ALTERATI DI QUELLI DEL MICROCITEMICO SANO: SONO QUASI COMPLETAMENTE PRIVI DI CONTENUTO EMOGLOBINICO, HANNO GRANDEZZA E FORME ASSAI DIVERSE, MOLTI SONO SOLTANTO DEI FRAMMENTI (SCHISTOCITI) ANZICHÈ VERI GLOBULI ROSSI, E TUTTI VANNO INCONTRO, A CAUSA DI QUESTE GRAVI ALTERAZIONI, AD UNA PRECOCE DISTRUZIONE.

I MALATI NON CURATI VANNO INCONTRO CON GLI ANNI A GRAVISSIME DEFORMAZIONI DEL CRANIO E DELLA FACCIA.

TERAPIA DELL’ANEMIA MEDITERRANEA I MALATI DI ANEMIA MEDITERRANEA HANNO BISOGNO DI RICEVERE SUBITO TRASFUSIONI DI SANGUE, CHE DEBBONO POI ESSERE PRATICATE PER TUTTA LA VITA AD INTERVALLI DI 15 -20 GIORNI. SOLO COSÌ VIVONO SENZA DEFORMAZIONI CRANIO-FACCIALI, RAGGIUNGONO LA GIOVINEZZA O L’ETÀ ADULTA E RIESCONO ANCHE A SPOSARSI E AD AVERE FIGLI.

DOPO 1 ANNO DALL’INIZIO DELLA TERAPIA CON EMOTRASFUSIONI IL PAZIENTE DEVE INIZIARE PERÒ UN’ALTRA TERAPIA, QUELLA FERROCHELANTE, CON UN FARMACO CHE RIESCE AD ELIMINARE ALMENO UNA PARTE DEL FERRO CHE SI ACCUMULA NEI SUOI ORGANI IN CONSEGUENZA DELLE EMOTRASFUSIONI. SENZA TERAPIA QUESTO ACCUMULO DI FERRO PROVOCA GIÀ NELL’ADOLESCENZA LA MORTE DEL PAZIENTE.

NELL’ADOLESCENZA IL PAZIENTE HA BISOGNO ANCHE DI UNA TERAPIA ORMONALE PER RAGGIUNGERE UN SUFFICIENTE SVILUPPO PUBERALE E, SE LA SUA MILZA È AUMENTATA MOLTO DI VOLUME O DISTRUGGE ESAGERATAMENTE IL SANGUE TRASFUSO, DEVE ESSERE OPERATO DI SPLENECTOMIA.

IL MALATO HA BISOGNO DUNQUE DI MOLTE E COMPLESSE CURE, SENZA TUTTAVIA GUARIRE. LA GUARIGIONE DEFINITIVA SI OTTIENE SOLO CON IL TRAPIANTO DI MIDOLLO OSSEO CHE PERÒ È LIMITATO AI PAZIENTI CHE ABBIANO UN FRATELLO O UNA SORELLA IDENTICI PER CARATTERI IMMUNOLOGICI.

OGGI IL TRAPIANTO SI ESEGUE TRASFONDENDO AL MALATO NON IL TESSUTO MIDOLLARE TOTALE DEL DONATORE MA SOLO LE SUE CELLULE STAMINALI E CIOÈ QUELLE CELLULE FORTEMENTE IMMATURE CHE HANNO LA PROPRIETÀ DI RIPRODURSI INDEFINITAMENTE E DI GENERARE UN ALTISSIMO NUMERO DI EMAZIE.

UN’ALTRA TERAPIA CHE POTREBBE DARE LA GUARIGIONE DEFINITIVA A TUTTI I MALATI È LA TERAPIA GENICA CHE PERÒ NON È ANCORA ATTUABILE.

LA TALASSEMIA INTERMEDIA È UNA MALATTIA CHE HA UN QUADRO SIMILE A QUELLO DELLA TALASSEMIA MAJOR, MA MENO GRAVE. I MALATI HANNO SVILUPPO FISICO E SOPRAVVIVENZA NORMALI. SONO ANEMICI MA NON TRASFUSIONE-DIPENDENTI. CON GLI ANNI VANNO INCONTRO A SIDEROSI DA IPERASSORBIMENTO DI FERRO ALIMENTARE, EPATO-SPLENOMEGALIA, ULCERAZIONI CRONICHE AGLI ARTI INFERIORI ED UN AGGRAVAMENTO DELL’ANEMIA CHE IN ETÀ AVANZATA PUÒ RENDERE NECESSARIA UNA REGOLARE TERAPIA EMOTRASFUSIONALE.

SI DISTINGUE UNA b TALASSEMIA INTERMEDIA CHE È CAUSATA DALL’OMOZIGOSI PER GENI b TALASSEMICI LIEVI O ADDIRITTURA SUB-SILENTI CHE DANNO LUOGO A b TALASSEMIA INTERMEDIA ASSAI LIEVE; E UN’a TALASSEMIA INTERMEDIA CHE È CAUSATA DALLA PRESENZA NEL GENOTIPO DEL MALATO DI UN GENE a MICROCITEMICO GRAVE ED UNO LIEVE. QUESTA VARIETÀ È CARATTERIZZATA DALLA PRESENZA DI UNA QUOTA DI Hb PIÙ RAPIDA DELL’Hb A E CIOÈ L’Hb H.

PREVENZIONE DELL’ANEMIA MEDITERRANEA LA NASCITA DI UN MALATO DI ANEMIA MEDITERRANEA SI PUÒ EVITARE CON CERTEZZA SE IL MICROCITEMICO DECIDE DI NON PROCREARE CON UN ALTRO MICROCITEMICO E SCEGLIE UN PARTNER NORMALE; OPPURE SE UNA COPPIA DI MICROCITEMICI (COPPIA A RISCHIO) DECIDE DI NON PROCREARE. QUESTA È LA PREVENZIONE PRE-CONCEZIONALE.

ESISTE PERÒ PER LE COPPIE A RISCHIO CHE VOLONTARIAMENTE O INCONSAPEVOLMENTE SI SIANO FORMATE E DECIDANO DI CONCEPIRE O ABBIANO GIÀ CONCEPITO UN FIGLIO, ANCHE UN MEZZO DI PREVENZIONE POST-CONCEZIONALE E CIOÈ LA DIAGNOSI PRENATALE NEL FETO E L’INTERRUZIONE DELLA GRAVIDANZA SE IL FETO RISULTA AMMALATO.


PER LA DIAGNOSI PRENATALE L’ESAME DEL FETO SI ESEGUE OGGI ATTRAVERSO LO STUDIO DEL DNA FETALE ESTRATTO DA UN FRAMMENTO DI VILLI CORIALI ALLA 10 a-12 a SETTIMANA DI GESTAZIONE. IL PRELIEVO DEI VILLI CORIALI SI ESEGUE CON UN APPOSITO AGO PER VIA TRANSADDOMINALE.

LA GRAVITÀ DEI PROBLEMI MORALI CHE QUESTA STRATEGIA PONE, HA SUBITO PROMOSSO LA RICERCA DI TECNICHE ALTERNATIVE CHE NON RICHIEDANO L’INTERRUZIONE DELLA GRAVIDANZA. QUESTE TECNICHE PRE-CONCEZIONALI SONO PERÒ ANCORA IN STUDIO E NON APPLICABILI IN PRATICA.

UNA DI QUESTE È LA TECNICA PRE-IMPIANTO CHE CONSISTE NEL SELEZIONARE GLI OOCITI CHE NELLE PRIME FASI DI MATURAZIONE HANNO ESPULSO LA CELLULA CONTENENTE LA MUTAZIONE MICROCITEMICA; FECONDARE QUESTI OOCITI E IMPIANTARLI IN UTERO.

AI FINI DELLA PREVENZIONE RESTA DUNQUE PIENAMENTE VALIDA LA STRATEGIA DELL’IDENTIFICAZIONE E DELL’INFORMAZIONE PRECOCI DEI GIOVANI MICROCITEMICI, CHE CONSENTE IL RICORSO ANCHE ALLA PREVENZIONE PRE-CONCEZIONALE, CHE SI REALIZZA PIENAMENTE ATTRAVERSO GLI SCREENING SCOLASTICI.

È EVIDENTE ANCHE LA NECESSITÀ CHE L’ESAME PER LA MICROCITEMIA SIA ESEGUITO PRESSO UN CENTRO SPECIALIZZATO CHE DIA UNA DIAGNOSI CERTA E CHE POSSA OFFRIRE AI GIOVANI MICROCITEMICI ANCHE LA NECESSARIA CONSULENZA GENETICA.

STATO ATTUALE DELLA PREVENZIONE IN ITALIA NEI VARI FOCOLAI MICROCITEMICI SI È GIÀ RAGGIUNTA UNA PREVENZIONE DI ALMENO IL 50%. NEL FERRARESE LA PREVENZIONE È GIÀ TOTALE. LA STRATEGIA È STATA QUELLA DELL’ESAME DELLE DONNE IN GRAVIDANZA E DELLA POPOLAZIONE GIOVANE-ADULTA.

SOLO NEL LAZIO È STATO APPLICATO UN PIANO DI PREVENZIONE MOLTO PIÙ COMPLETO ED ARTICOLATO, CHE REALIZZA NON SOLO L’ESAME DI DONNE IN GRAVIDANZA MA ANCHE L’ESAME DI TUTTA LA POPOLAZIONE DI ADOLESCENTI TRAMITE UNO SCREENING SCOLASTICO.

CON IL PATROCINIO E IL FINANZIAMENTO DELLA REGIONE LAZIO LO SCREENING SCOLASTICO DEI MICROCITEMICI SI ESEGUE REGOLARMENTE ORMAI DA 25 ANNI CONSECUTIVI. HA PRODOTTO UN NOTEVOLE SVILUPPO DELLE CONOSCENZE SULLE MICROCITEMIE IN TUTTA LA POPOLAZIONE E SOPRATTUTTO HA RAGGIUNTO GIÀ DA ALCUNI ANNI L’OBBIETTIVO CENTRALE DI UNA COMPLETA CESSAZIONE DELLE NASCITE DI NUOVI MALATI IN TUTTA LA REGIONE.



MESSAGGIO CONCLUSIVO GIOVANI ! FATE TUTTI L’ESAME PER LA MICROCITEMIA PRIMA DEL FIDANZAMENTO O DEL MATRIMONIO. SE SIETE PORTATORI SANI DI MICROCITEMIA, FATE SEMPRE ESAMINARE PER LA MICROCITEMIA, PRIMA DI CONCEPIRE UN FIGLIO, IL VOSTRO PARTNER PRESSO UN CENTRO SPECIALIZZATO.

SE SPOSERETE UN SOGGETTO NORMALE NON AVRETE FIGLI MALATI DI ANEMIA MEDITERRANEA. SE SPOSERETE UN MICROCITEMICO POTRETE EVITARE EGUALMENTE DI AVERE FIGLI MALATI SE ALL’INIZIO DELLA GRAVIDANZA FARETE ESEGUIRE LA DIAGNOSI PRENATALE SUL FETO PRESSO UN CENTRO SPECIALIZZATO.

DONNE ! ALL’INIZIO DI OGNI GRAVIDANZA, SE NON L’AVETE ANCORA FATTO E ANCHE SE AVETE GIÀ ALTRI FIGLI SANI, FATE SUBITO L’ESAME PER LA MICROCITEMIA E, IN CASO DI RISULTATO POSITIVO, FATE SUBITO ESAMINARE ANCHE IL VOSTRO PARTNER.

L’ANEMIA DREPANOCITICA E LA MALATTIA MICRODREPANOCITICA SONO MALATTIE TIPICHE DEI PAESI AFRICANI, MA DA SEMPRE PRESENTI ANCHE IN ITALIA E OGGI PIÙ FREQUENTI A SEGUITO DELLA CRESCENTE IMMIGRAZIONE DI POPOLAZIONI DAL CONTINENTE AFRICANO. AMBEDUE SONO CARATTERIZZATE DALLA PRESENZA DELLA FALCEMIA (O DREPANOCITOSI O Hb S) E CIOÈ DI UN’EMOGLOBINA ANOMALA CHE HA ORIGINE DA UNA MUTAZIONE NEL GENE b GLOBINICO.

COME LA MICROCITEMIA, ANCHE LA FALCEMIA SI TRASMETTE EREDITARIAMENTE COME UN CARATTERE MENDELIANO DOMINANTE.

L’ANEMIA DREPANOCITICA È CAUSATA (v. figura) DALLA CONDIZIONE OMOZIGOTICA DEL GENE PER L’Hb S (figurina tutta azzurra). LA MALATTIA MICRODREPANOCITICA (figurina metà rossa e metà bianca) È CAUSATA DALL’ASSOCIAZIONE DELLA FALCEMIA CON UN DIFETTO b MICROCITEMICO. QUESTA MALATTIA È STATA SCOPERTA E DESCRITTA IN ITALIA NEL 1944 DA SILVESTRONI E BIANCO IN UN SOGGETTO DI RAZZA BIANCA.

CARATTERISTICHE FUNZIONALI DELL’Hb S QUESTA EMOGLOBINA HA, A p. H ALCALINO, UNA MOBILITÀ ELETTROFORETICA ASSAI MINORE DI QUELLA DELL’Hb A.

IN MANCANZA DI OSSIGENO L’Hb S DIVIENE INSOLUBILE DENTRO LE EMAZIE CHE DI CONSEGUENZA ASSUMONO UNA FORMA ALLUNGATA E RICURVA SIMILE A QUELLA DI TANTE FALCI (FENOMENO FALCIFORME).

DAL LATO EMOGLOBINICO IL MALATO DI ANEMIA DREPANOCITICA PRESENTA OLTRE AD UNA MODESTA QUOTA DI Hb F E UNA NORMALE DI Hb A 2, SOLTANTO Hb S. IL MALATO DI MALATTIA MICRODREPANOCITICA PUÒ AVERE, OLTRE A QUESTE Hb, ANCHE UNA PICCOLA QUOTA DI Hb A, SE LA MUTAZIONE MICROCITEMICA È UNA b+ MICROCITEMIA.

ECCO L’ASPETTO ELETTROFORETICO DELL’Hb NELLE DUE MALATTIE FALCEMICHE.

CARATTERI CLINICI DELLE MALATTIE FALCEMICHE IL QUADRO CLINICO È CARATTERIZZATO IN ENTRAMBE LE MALATTIE DA CRISI DOLOROSE IMPROVVISE, VIOLENTE E RICORRENTI CON LOCALIZZAZIONE OSSEA, ARTICOLARE E MUSCOLARE; OPPURE VISCERALE (POLMONARE, ADDOMINALE). POSSONO INSORGERE, SPECIALMENTE NELL’ANEMIA DREPANOCITICA, MANIFESTAZIONI NEUROLOGICHE ED ANCHE ICTUS CEREBRALI. TUTTE QUESTE MANIFESTAZIONI SONO CAUSATE DA TROMBOSI ED INFARTI CONSEGUENTI ALLA MASSICCIA DEFORMAZIONE A FALCE DELLE EMAZIE IN CIRCOLO.

IL QUADRO EMATOLOGICO HA NELLA MALATTIA MICRODREPANOCITICA I CONSUETI CARATTERI EMATOLOGICI MICROCITEMICI, MENTRE NELL’ANEMIA DREPANOCITICA HA SOLTANTO I CARATTERI DI UN’ANEMIA NORMOCROMICA PIÙ O MENO GRAVE. INCUBANDO IL SANGUE A 37°C IN CONDIZIONI DI ANOSSIEMIA IL FENOMENO FALCIFORME COMPARE, MOLTO ACCENTUATO, IN POCHE ORE.

TERAPIA OGGI I MALATI REGOLARMENTE CURATI RAGGIUNGONO QUASI SEMPRE L’ETÀ ADULTA ED OLTRE. HANNO BISOGNO DI TERAPIA TRASFUSIONALE NON SOLO PER COMBATTERE L’ANEMIA MA ANCHE PER RIDURRE LA QUOTA DI Hb S NEL SANGUE CIRCOLANTE CHE È LA CAUSA DI TUTTE LE COMPLICANZE CLINICHE. È UTILE ANCHE LA TERAPIA CON IDROSSIUREA, UN FARMACO CHE È CAPACE DI STIMOLARE LA SINTESI DI Hb F.

NEL CORSO DELLE CRISI DOLOROSE È INDISPENSABILE L’APPORTO DI MOLTI LIQUIDI E UN’INTENSA TERAPIA ANTIDOLORIFICA. SE LA MILZA RAGGIUNGE GRANDI DIMENSIONI O DISTRUGGE ESAGERATAMENTE IL SANGUE TRASFUSO, OCCORRE LA SPLENECTOMIA.

PREVENZIONE ANCHE PER LE MALATTIE FALCEMICHE È POSSIBILE LA PREVENZIONE CON GLI STESSI INTERVENTI CHE SI APPLICANO NELL’ANEMIA MEDITERRANEA.

IN ITALIA I PROGRAMMI DI PREVENZIONE SONO NECESSARI PERÒ SOLO PER LE REGIONI MERIDIONALI E SOPRATTUTTO IN SICILIA E IN CALABRIA IN CUI AMBEDUE LE ANOMALIE (MICROCITEMIA E FALCEMIA) SONO FREQUENTI.
- Slides: 71